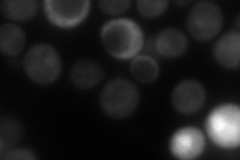
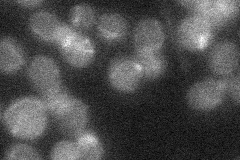
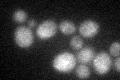
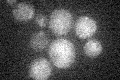

View description
tRNA:pseudouridine synthase, catalyzes the conversion of uridine to pseudouridine at position 31 in cytoplasmic and mitochondrial tRNAs; mutation of Asp168 to Ala abolishes enzyme activity; not essential for viability
Localization:
Intensity:
Fold change:
Significance:
-
C’ GFP library in SD

ambiguous20.84 -
N' NOP1pr-GFP in SD

cytosol86.4884 -
N' TEF2pr-mCherry in SD
cytosol106.496 -
N' NATIVEpr-GFP in SD
below threshold20.3823 -
N' TEF2pr-VC and Cyto-VN in SD

#N/A0 -
C’ GFP library in SD+DTT
ambiguous18.090.86No -
C’ GFP library in SD+H2O2

ambiguous19.550.93No -
C’ GFP library in Starvation Media
ambiguous14.650.7No -
C’ GFP library on the background of Pup2-DaMP

ambiguous -
C’ GFP library on the background of CCT mutant

ambiguous26.38731.26579No
